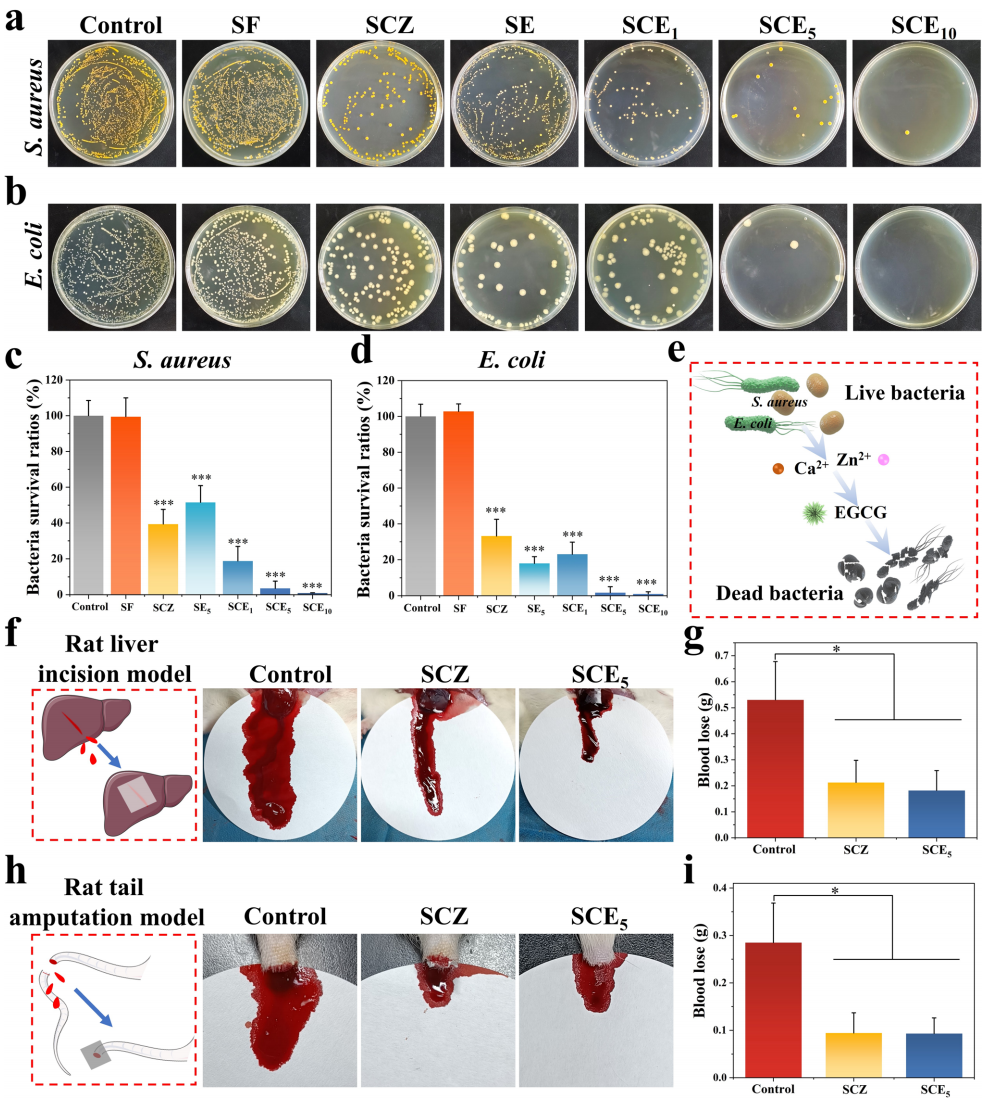
image (7).png

全球约 40% 死亡与纤维化相关,创伤、烧伤、手术等导致的皮肤损伤易形成增生性疤痕(HS),影响 1 亿患者生活,现有手术、激光等疗法复发率高、效果不佳。伤口愈合需经历止血、炎症、增殖、重塑四阶段,血管生成在各阶段均起关键作用,过度血管生成易致疤痕,需序贯调控微环境以实现无疤痕愈合。持续的伤口愈合微环境调控和及时的血管生成调控,对于防止胶原蛋白过度积累、促进无疤痕伤口愈合至关重要。

近期,南方科技大学郭金山教授、胡志奇教授等人开发了一种双层丝素蛋白(SF)基 Janus 粘性敷料(SCE),其下层为 Ca²⁺/Zn²⁺修饰的丝素蛋白(SCZ),上层为核壳结构丝素蛋白电纺纤维(SE),核心封装表没食子儿茶素没食子酸酯(EGCG)。Ca²⁺/Zn²⁺修饰可诱导丝素蛋白去结晶化,使下层 SCZ 具备强组织粘附性,与伤口接触后能快速止血并发挥初期抗炎作用。宏(双层)/ 微(核壳)双设计使 EGCG 在愈合早期缓慢释放,与 Zn²⁺协同发挥抗氧化和抗炎作用;随着下层完全吸收、上层壳层降解,大量 EGCG 在愈合后期持续释放,从而抑制血管生成。基于大鼠全层皮肤伤口模型和兔耳疤痕模型的体内实验进一步证实,SCE 敷料兼具早期止血、抗菌、抗氧化、抗炎功效与后期血管生成抑制作用,可减少血管密度和血供,进而促进细胞外基质重塑、防止胶原蛋白过度生成与沉积,具有显著的无疤痕伤口愈合潜力。相关研究成果以“Janus Adhesive Dressing with Macro/Micro Dual Design Enabling Sequential Microenvironment Regulation for Scarless Wound Healing”为题目,发表在期刊《Advanced Fiber Materials》上。

Scheme 1 具有宏/微双设计的 Janus 双面粘性敷料的开发 —— 实现微环境序贯调控以促进无疤痕伤口愈合。

图 1 丝素蛋白基 Janus 粘性敷料的表征。

图 2 物理性能、力学性能、降解性能及 EGCG 释放性能。

图 3 细胞相容性评价。

图 4 抗氧化及抗炎活性。

图 5 血管生成抑制作用评价。
图 6 抗菌活性及止血性能。

图 7 兔耳疤痕形成预防的在体评价。
结论:
本研究针对创伤后疤痕形成这一关键临床难题,开发了 SCE Janus粘性敷料。该敷料的亲水性上层主要由核内封装表没食子儿茶素没食子酸酯(EGCG)的丝素蛋白电纺纤维构成,疏水性下层则为 Ca²⁺/Zn²⁺修饰的丝素蛋白电纺膜。此外,SCE Janus 双面粘性敷料具有粘附性、可降解性和生物相容性等特点。更重要的是,它可作为 “生物计时器” 调控伤口愈合,防止创伤后疤痕过度形成。
具体而言,该敷料通过在伤口炎症期发挥抗炎作用、增殖期抑制伤口床过度血管生成、重塑期限制导致疤痕形成的胶原蛋白过度沉积,从而实现促愈合及无疤痕愈合效果。在大鼠伤口模型中,SCE Janus 双面粘性敷料可快速促进伤口愈合;在兔耳疤痕模型中,其通过在伤口愈合不同阶段发挥作用,显著减少疤痕形成。兔耳组织的 RNA 测序分析表明,该敷料的作用机制主要为:炎症期抑制炎症反应、增殖期抑制血管生成、重塑期调控胶原蛋白沉积。综上,SCE Janus 双面粘性敷料具有广泛的治疗应用潜力,可用于皮肤伤口治疗及疤痕形成预防。
原文链接:https://doi.org/10.1007/s42765-025-00620-y